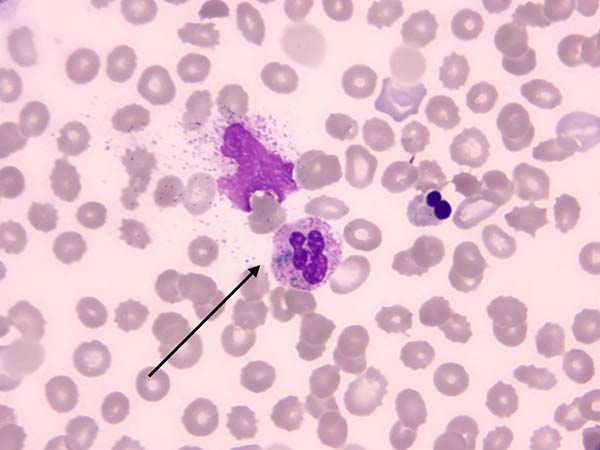

科普文章
【杨柳科普】蓝绿色包涵体:外周血检查中的危险信号
蓝绿色包涵体(Green Inclusion,GI)是一种在中性粒细胞或单核细胞胞浆内出现的蓝绿色包涵体,因其颜色和形态特征而得名。其颜色呈浅染或深染的蓝色或墨绿色,形状为球状或块状,有折光性。可单个散在或多个出现。因其在临床上极为罕见,且与高死亡率密切相关,故被称为“临终绿色包涵体”或“绿色死亡颗粒”。如下图所示:

一.来源与形成机制
蓝绿色包涵体的具体来源尚不明确,但多数研究推测其与肝病有关,并认为是中性粒细胞和单核细胞吞噬了肝细胞损伤的产物,为胆汁相关物质或溶酶体降解产物。Harris等人提示绿色包涵体可能是一种胆汁相关产物胆绿素,但确实无特殊的胆绿素染色方法来证实。Hodgson等对2例患者外周血中性粒细胞进行了透射电镜观察,中性粒细胞胞浆中包涵体与光学显微镜下特征一致。包涵体具有嗜锇特性,揭示其富含脂质成分,推测由胞膜或囊泡组成,并通过染色将此类色素归为脂褐素,为中性粒细胞或单核细胞吞噬了缺血性肝炎损伤时释放的脂褐素样物质或其他溶酶体降解产物。
二.临床意义
大多数报道中性粒细胞绿色包涵体见于肝衰竭的危重患者,也可见于多种重症疾病患者,包括产气荚膜梭菌脓毒症、脑膜炎病等。伴随乳酸中毒的患者,出现此类包涵体常伴随转氨酶急剧升高,随后病情迅速恶化,并于72小时内死亡。其病死率高达58%-68%,如发现此类包涵体应尽快和临床沟通。因其非常罕见,我们对它的认识还是有限的,为此需要积累更多的临床案例来证实其价值。
三.结语
从检验科的角度而言,我们应该了解这类异常包涵体的形态特点,与其他内含物进行鉴别。尽可能地通过镜检识别它,并及时联系临床,把信息传递给临床,方便临床全面掌握患者情况,采取必要的治疗措施。
参考文献
1. Vicente-Steijin R , Tome A ,Maduell F , et al.Green inclusions in neutrophils: A critical finding that must be reported[J].2020,42(3).
2. 黄仙圣,曹顺旺,吴敏君,谢学贤,陈丽,隋洪.肺腺癌患者外周血白细胞检出包涵体1例[J].临床检验杂志,2023,41(6):477-478.DOI:10.13602/j.cnki.jcls.2023.06.19.
3. 唐文佳,朱建锋,王蓓丽,潘柏申,郭玮.肝移植后肝功能衰竭伴中性粒细胞内绿色小体1例[J].中华检验医学杂志,2023,46(7):738-740.DOI:10.3760/cma.j.cn114452-20220913-00528.
4. 本文仅限于公益科普及学术交流,如有不适请及时就医。文中部分资料来源文献及网络,侵删。
- 标签:
- 检验科
上一篇: 【杨柳科普】漱口水,你真的用对了吗?
下一篇: 【杨柳科普】漏斗胸 | 护理知识小课堂









 京公网安备11010502033717号
京公网安备11010502033717号